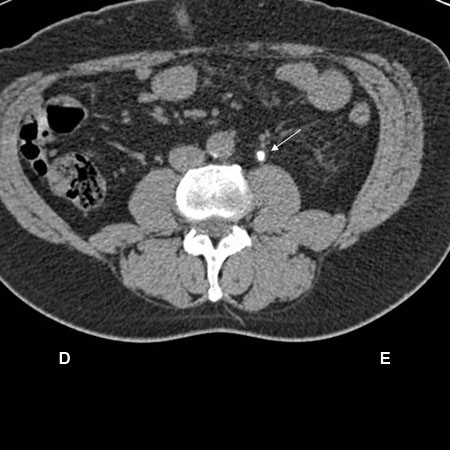

Resumo
Diagnósticos diferenciais
comuns
- Cistite
- Uretrite
- Pielonefrite
- Vulvovaginite (incluindo vaginose bacteriana)
- Balanite/balanopostite
- Prostatite aguda
- Hiperplasia prostática benigna
- Urolitíase
- Irritantes locais
Incomuns
- Vírus do herpes simples (HSV) genital
- Epidídimo-orquite
- Cervicite
- Esquistossomose
- Tuberculose (TB)
- Estenose uretral
- Intervenção ou cateterismo
- Abuso sexual
- Esportes
- Cistite intersticial
- Vaginite atrófica
- Espondiloartropatias
- Prostatite não infecciosa
- Síndrome da dor prostática primária
- Bexiga inflamada pela cetamina
- Fístula urinária
- Câncer de próstata
- Câncer de bexiga
- Câncer renal
- Câncer cervical
- Câncer uretral
- Câncer peniano
- Medicamentos ou fitoterápicos
Colaboradores
Autores
Kasra Saeb-Parsy, BSc, MBBS, AFHEA, FRCSEd (Urol)

Consultant Urologist
Cambridge University Hospitals NHS Foundation Trust
Cambridge
UK
Honorary Lecturer
Anglia Ruskin University
Cambridge
UK
Declarações
KS-P declares that he has no competing interests.
Sarah R. Saifuddin, BSc (Hons), MBBS, MRCS
Urology Specialty Registrar
Cambridge University Hospitals NHS Foundation Trust
Cambridge
UK
Declarações
SRS declares that she has no competing interests.
Agradecimentos
Kasra Saeb-Parsy and Sarah R. Saifuddin would like to acknowledge Dr Elaine Lee and Dr Vincent J. Gnanapragasam, the previous contributors to this topic.
Declarações
EL and VJG declare that they have no competing interests.
Revisores
Robert Pickard, MD, FRCS (Urol)
Professor of Urology
Institute of Cellular Medicine
Newcastle University
Newcastle upon Tyne
UK
Declarações
RP has received funding from the UK NHS (NIHR) to undertake commissioned reviews of treatment for benign prostatic enlargement.
George Martin, MD
Instructor
Department of Urology
Mayo Clinic
Scottsdale
AZ
Declarações
GM declares that he has no competing interests.
Créditos aos pareceristas
Os tópicos do BMJ Best Practice são constantemente atualizados, seguindo os desenvolvimentos das evidências e das diretrizes. Os pareceristas aqui listados revisaram o conteúdo pelo menos uma vez durante a história do tópico.
Declarações
As afiliações e declarações dos pareceristas referem--se ao momento da revisão.
Referências
Principais artigos
European Association of Urology. Guidelines on urological infections. Apr 2024 [internet publication].Texto completo
American College of Radiology. ACR appropriateness criteria: acute pyelonephritis. 2022 [internet publication].Texto completo
American College of Radiology. ACR appropriateness criteria: recurrent lower urinary tract infections in females. 2020 [internet publication].Texto completo
American College of Radiology. ACR appropriateness criteria: lower urinary tract symptoms-suspicion of benign prostatic hyperplasia. 2019 [internet publication].Texto completo
Artigos de referência
Uma lista completa das fontes referenciadas neste tópico está disponível aqui.
O uso deste conteúdo está sujeito ao nosso aviso legal